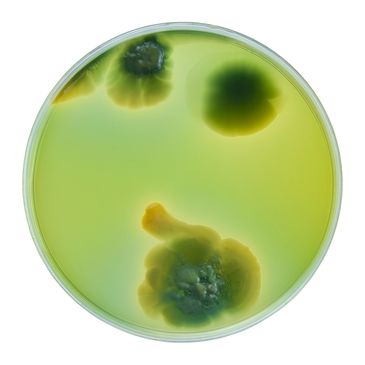

We proudly offer discounts for Military, Fire and Police Personnel!
What We Do

Water Damage
Mold Remediation
Water Damage
From burst pipes to storm floods, water damage can strike at any time. Our expert team responds quickly to extract water, dry affected areas, and prevent further structural damage or mold growth. We use advanced moisture detection tools and industry-leading drying techniques to ensure your property is completely restored.

Fire & Smoke
Mold Remediation
Water Damage
A fire can leave behind not only visible destruction but also pervasive smoke and soot damage. We handle all aspects of fire restoration, including debris removal, soot and odor control, structural repairs, and content cleaning.
Mold Remediation
Mold Remediation
Mold Remediation
Mold can threaten both your property and your health. Our certified mold remediation experts identify the source of moisture, safely remove mold colonies, and treat affected areas to prevent future growth. We follow strict containment and cleaning protocols to keep you and your family safe.
Our Work
Instagram
This website uses cookies.
We use cookies to analyze website traffic and optimize your website experience. By accepting our use of cookies, your data will be aggregated with all other user data.